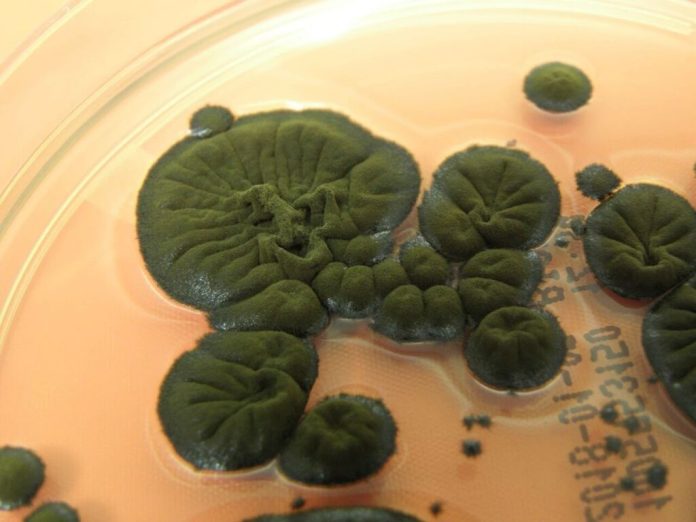

ჩერნობილის აკრძალული ზონა შეიძლება ადამიანებისთვის მიუწვდომელი იყოს, მაგრამ მას შემდეგ, რაც თითქმის 40 წლის წინ ჩერნობილის ატომური ელექტროსადგურის მეოთხე რეაქტორი აფეთქდა, სიცოცხლის სხვა ფორმები იქ არა მხოლოდ შევიდნენ, არამედ გადარჩნენ, ადაპტირდნენ და როგორც ჩანს, აყვავდნენ კიდეც.
ამის ერთი მიზეზი შეიძლება იყოს ის, რომ იქ ადამიანები არ არიან… მაგრამ სულ მცირე ერთი ორგანიზმისთვის, უპირატესობა შეიძლება იყოს რეაქტორის მიმდებარე სტრუქტურებში ჩარჩენილი იონიზირებადი რადიაცია.
იქ, დედამიწაზე ერთ-ერთი ყველაზე რადიოაქტიური შენობის შიდა კედლებზე, მეცნიერებმა იპოვეს უცნაური შავი სოკო, რომელიც იქ საუკეთესო „ცხოვრებით ცხოვრობს“.
ამ სოკოს სახელია Cladosporium sphaerospermum-ი და ზოგიერთი მეცნიერის აზრით, მისი შავი პიგმენტი — მელანინი —საშუალებას უნდა აძლევდეს აითვისოს იონიზირებადი რადიაცია ისეთი პროცესით, რომელსაც მცენარეები სინათლეს იყენებენ ფოტოსინთეზისთვის. ამ სავარაუდო მექანიზმს მეცნიერებმა რადიოსინთეზი უწოდეს.
თუმცა, C. sphaerospermum-ის შესახებ არის ერთი უცნაური რამ — მართალია, მეცნიერებმა აჩვენეს, რომ სოკო გადასარევად გრძნობს თავს იონიზირებად რადიაციაში, ვერავინ შეძლო იმის დადგენა, როგორ ან რატომ. რადიოსინთეზი მხოლოდ თეორიაა და მისი დამტკიცება რთულია.
იდუმალება 1990-იანი წლების ბოლოს დაიწყო, როცა ჯგუფმა უკრაინის მეცნიერებათა აკადემიის მიკრობიოლოგ ნელი ჟდანოვას ხელმძღვანელობით, ჩერნობილის აკრძალულ ზონაში საველე კვლევა დაიწყო, რათა დაედგინათ არსებობდა თუ არა რაიმე სახის სიცოცხლე დანგრეული რეაქტორის გარშემო.
მათ გაოცებას საზღვარი არ ჰქონდა, როცა იქ სოკოების მთელი საზოგადოება აღმოაჩინეს. ჯამში აღრიცხეს 37 სახეობა. აღსანიშნავია, რომ ეს ორგანიზმები მუქი, მოშავო შეფერილობის არიან, პიგმენტ მელანინით მდიდარი.
ნიმუშებში ჭარბობდა C. sphaerospermum-ი, რომელშიც ასევე აღინიშნებოდა რადიოაქტიური დაბინძურების ყველაზე მაღალი დონე.
რამდენადაც გასაოცარი იყო აღმოჩენა, ინტრიგა კიდევ უფრო გააღრმავა იმან, რაც შემდეგ მოხდა.
აშშ-ის ალბერტ აინშტაინის სამედიცინო კოლეჯის რადიოფარმაკოლოგმა ეკატერინა დადაჩოვამ და იმუნოლოგმა არტურო კასადევალმა დაადგინეს, რომ იონიზირებადი რადიაციის ზემოქმედება C. sphaerospermum-ს ისე არ აზიანებდა, როგორც ეს სხვა ორგანიზმების შემთხვევაში ხდება.
იონიზირებადი რადიაცია არის ნაწილაკთა გამოსხივების სახე, რომელიც იმდენად ძლიერია, რომ ელექტრონები ატომებიდან ვარდება და მათ იონურ ფორმებად გარდაქმნის.
თითქოს დიდი არაფერი, მაგრამ პრაქტიკაში, იონიზაციას შეუძლია დაანგრიოს მოლეკულები, ჩაერიოს ბიოქიმიურ რეაქციებში და დნმ-ც კი დაშალონ. ადამიანისთვის არცერთი ეს ქმედება კარგი არ არის, მაგრამ ამის გამოყენება შესაძლებელია კიბოს უჯრედების გასანადგურებლად, რომლებიც ამ ეფექტებისადმი განსაკუთრებით მოწყვლადნი არიან.
თუმცა, C. sphaerospermum-ი უცნაურად რეზისტენტული ჩანდა და უკეთესადაც კი იზრდებოდა, როცა იონიზირებადი რადიაცია ხვდებოდა. სხვა ექსპერიმენტებმა აჩვენა, რომ იონიზირებადი რადიაცია სოკოს მელანინის ქცევას ცვლიდა — დამაინტრიგებელი დაკვირვება, რომელიც დამატებით შესწავლას საჭიროებს.
შემდეგ კვლევაში, 2008 წელს, დადაჩოვამ და კასადევალმა პირველად ივარაუდეს ფოტოსინთეზის მსგავსი ბიოლოგიური გზის შესახებ.
ისე ჩანდა, რომ ეს სოკო და სხვა მისი მსგავსები, მაიონიზებელ რადიაციას ითვისებდნენ და მას ენერგიად გარდაქმნიდნენ, მელანინი კი ისეთივე ფუნქციას ასრულებდა, როგორსაც სინათლის შთანმთქმელი პიგმენტი ქლოროფილი.
ნათარგმნია მიხეილ ჭაბუკაშვილის მიერ – 1tv.ge
ასევე ნახეთ:
რომელ დღეებში ჯობს ნაძვის ხის დადგმა, რომ სახლში ფინანსური წარმატება მოიზიდოთ
როდის ენიშნება არასრულწლოვანს პენსია და ვინ ითვლება მარჩენალდაკარგულად
ქალი მასწავლებელი, რომელმაც მსოფლიო შეცვალა
iPhone: https://apps.apple.com/fr/app/sheni/id6746877342?l=en-GB
Telegram არხი: https://t.me/SheniEkimi